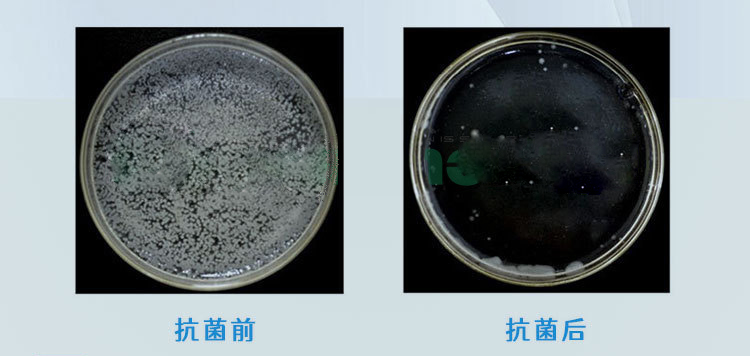
4298_01.jpg

塑料銀離子透明抗菌劑,具有廣譜性、持久性。金志成為提高銀離子抗菌劑在塑料制品中的分散效果,在銀離子抗菌粉基礎上,接受定制塑料載體無機抗菌母粒和抗菌防霉母粒,可以直接添加到塑料中使用,起到抗菌作用。
銀離子抗菌母粒是我司采用銀系無機抗菌粉體為作為活性抗菌成分,選用塑料原料為載體,采用分散技術和制造工藝生產的抗菌功能母粒,是塑料定制抗菌母粒。銀系抗菌粉的含量為20%,也可按照需求定制不同抗菌粉體含量的專用母粒。具有良好的抑菌、殺菌效果。它具有抑菌效果好、不易變色等優點,對樹脂基材具有優異的改性作用,同時不影響PP制品的力學性能。

深圳市金志成塑膠(阻燃)有限公司成立于2003年4月。公司以磷系阻燃母粒、氮系阻燃母粒、溴系阻燃母粒、阻燃改性塑料為主,主營產品有色母粒、功能性母粒、PP環保阻燃母粒、PE阻燃母粒、PC透明阻燃母粒、PET無鹵阻燃母粒、PA阻燃母粒、防火我、片材、板材阻燃母粒、薄膜阻燃母粒、化纖絲阻燃母粒等一系列塑膠阻燃產品。公司已經通過ISO9001:國際品質認證及美國UL安規認證的同時,產品經SGS等認證機構檢驗達到環保標準。
公司同時擁有一支長期從事阻燃及塑料改性研發生產的專業工程師、技師、熟練操作工人以及具有一定管理經驗和開拓創新精神的管理人員隊伍。公司生產設備先進、檢測設備完善。配備有注塑機、雙螺桿擠出機、臺式分光測色儀、電子萬能試驗機、熱變形維卡軟化點測定儀等專用檢測儀器。公司主要產品有薄膜阻燃母粒、流延膜阻燃母粒、板材阻燃母粒、片材阻燃母粒、管材阻燃母粒、紡絲阻燃母粒,淋膜阻燃母粒及各種功能性阻燃母粒等。主要用于戶外塑膠制品等多個領域,品種齊全。
咨詢:PE/PP/PC/ABS (環保)抗菌母粒